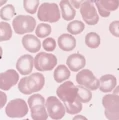
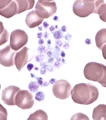
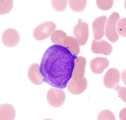
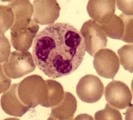
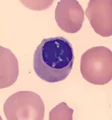

Featured Quizzes
User Quizzes
Create Quiz
Data and Charts
Word Search
Flash Cards
Badges and Games
About JetPunk
Message Board
Dark Mode
Name the blood cell - Statistics
General Stats
- This quiz has been taken 49 times
- The average score is 4 of 15
Answer Stats
| Picture | Answer | % Correct |
|---|---|---|
| Red Blood Cell (RBC) | 77%
|
 | Lymphocyte | 67%
|
| Platelet | 54%
|
 | Monocyte | 49%
|
 | Basophil | 44%
|
 | Eosinophil | 38%
|
 | Megakaryocyte | 13%
|
 | Mast Cell | 10%
|
| Blast | 8%
|
| Neutrophil (Segmented) | 8%
|
 | NK/LGL Cell | 8%
|
 | Plasma Cell (Plasmocyte) | 8%
|
 | Metamyelocyte | 5%
|
 | Myelocyte | 5%
|
| Normoblast (NRBC) | 5%
|
No matching quizzes found
Score Distribution
Percent of People with Each Score
Percentile by Number Answered
Your Score History
You have not taken this quiz
New and Popular
